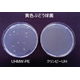
?クリンピーUH 画像.png
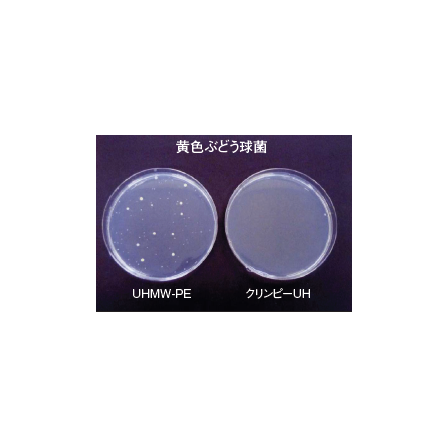
?クリンピーUH 画像.png
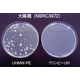
?クリンピーUH 画像2.png
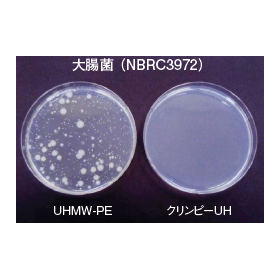
?クリンピーUH 画像2.png

抗菌超高分子量ポリエチレン樹脂素材『クリンピーUH』
抗菌・防カビグレード!耐薬品性に優れ、摺動部材としても好適です
『クリンピーUH』は、抗菌性能試験、カビ抵抗性試験及び食品衛生法に 合格した抗菌超高分子量ポリエチレン樹脂素材です。 当製品と、抗菌処理を施していない超高分子量ポリエチレンについて 抗菌性能試験を行った結果、黄色ぶどう球菌及び大腸菌において、 菌の発育が抑えられていることを確認。 また、耐候区分1、耐水区分3においてJIS規格である抗菌活性値、 ≧2.0を満たしました。 【特長】 ■低摩擦 ■耐摩耗 ■耐薬品 ※詳しくはPDFをダウンロードしていただくか、お気軽にお問い合わせください。
基本情報
【製造可能範囲】 ■板:厚み3~50mm ■丸棒:直径10~200mm ※詳しくはPDFをダウンロードしていただくか、お気軽にお問い合わせください。
価格帯
納期
用途/実績例
【用途】 ■食品機械など ※詳しくはPDFをダウンロードしていただくか、お気軽にお問い合わせください。
カタログ(1)
カタログをまとめてダウンロードおすすめ製品
取り扱い会社
株式会社カテックス:未来を創るグローバルパートナー 1934年創業の株式会社カテックスは、工業用品、自動車部品、建設資材を提供する企業です。自社およびグループ企業の工場では、プラスチック成形・加工、金型、ゴム材料・成形を行い、幅広いニーズに対応。海外に製造拠点や商社を展開し、中国、ベトナム、シンガポール、フィリピン、インドネシアなどで豊富な経験を持つスタッフが活躍しています。 品質管理と環境問題に積極的に取り組み、持続可能な社会の実現を目指しています。創業以来、東海地方を中心に地元有力企業の製造現場を支え、信頼と実績を築いてきました。さらに、自社設計のメカトロ部を設立し、製品ラインナップを拡充。これにより、より多様なニーズに応えることが可能となりました。 株式会社カテックスは、成長と革新を追求し、未来を共に築くパートナーとして邁進してまいります。詳細については、公式サイトをご覧ください。